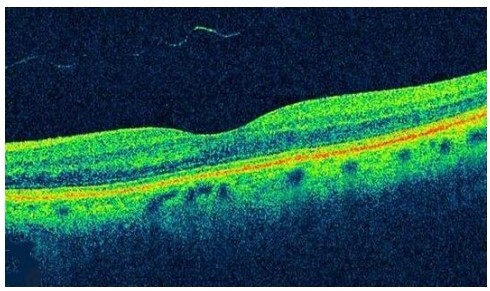

Du er læge i almen praksis og ser et 4-årigt barn til rutinemæssig børneundersøgelse.
Barnet koopererer fint og holder koncentrationen gennem undersøgelsen.
Ved din objektive undersøgelse finder du følgende:
Visus o. dx.: 1,0 (6/6).
Visus o.sin.: 0,3 (6/18).
Ved Hirschbergs test og tildækningsprøve: Skelen på venstre øje.
Gennemlysning: Normal med fine røde reflekser o.u.
Hvad gør du nu?
A. Fornyet kontrol i din praksis om 6 mdr.
B. Henviser direkte til praktiserende øjenlæge.
C. Henviser direkte til nærmeste øjenafdeling.
D. Gør intet, da skelen er normalt hos børn i denne alder.
E. Opstarter plasterbehandling af barnets gode, højre øje med det samme.
B. Henviser direkte til praktiserende øjenlæge.
Note:
Behandling af skelen er brillekorrektion samt amblyopi-behandling dvs. plaster for det raske øje for at undgå, at det bliver dovent.
A: Forkert - barnet skeler og det skal behandles.
B: Korrekt - øjenlægen skal undersøge barnet og igangsætte behandling.
C: Forkert - det er til praktiserende øjenlæge.
D: Forkert - det er ikke normalt og det skal behandles.
E: Forkert - det er korrekt, at der skal opstartes plasterbehandling af barnets gode højre øje for at undgå dovent øje, men det skal ikke gøres med det samme. Man starter først med brillekorrektion, men hvis det andet øje allerede er blevet dovent (amblyopi), da igangsætter man klapbehandling.
BONUS:
Rød refleks: for medfødt katarakt
Hirschbergs test: en test til at vurdere om man har skelen (se billede)
Tildækningsprøve: skelner mellem konstant skelen og latent skelen.

Optisk kohærens tomografi (OCT) kan bruges til at visualisere et tværsnit af hvilken del af øjet?
A. Cornea.
B. Iris.
C. Linsen.
D. Glaslegemet.
E. Retina.
E. Retina.
Note:
Husk på at man bruger OCT til AMD (våd) for at se efter ødem af makula (den gule plet–>et sted på retina, hvor der er høj tæthed af tappe og som sørger for vi kan se skarpt og nært).
Hvilken nerve innerverer m. levator palpebrae og er dermed primært ansvarlig for løft af øjenlåget og åbning af øjet? Den vil ved kompromittering føre til varierende grader af ptose.
A. n. opticus (II)
B. n. oculomotorius (III)
C. n. trochlearis (IV)
D. n. trigeminus (V)
E. n. facialis (VII)
B. n. oculomotorius (III)
Note:
N. abducens innerverer m. rectus lateralis
N. trochelaris innerverer m. subliqus superior
N. oculomotorius innerverer m. rectus medialis, m. rectus superior, m. rectus inferior, m. obliquus inferior og m. levator palpebrae.
Hvilke af følgende forandringer kan man observere på nethinden hos en patient med diabetisk retinopati?
- Mikroaneurismer.
- Spiculae.
- Atrofiske forandringer.
- Præretinale karnydannelser.
- Cotton wool spots.
Svarmuligheder:
A. 1+4+5
B. 1+2+3
C. 3+4+5
D. 1+3
E. 2+5
A. 1+4+5
Note: kort fortalt om diabetisk retinopati.
Diabetespatienter har ofte et højere blodglukose end normalt og de høje sukkerkoncentrationer kan medføre tab af blodkar i retina og dermed iskæmi. Der vil på baggrund heraf være en overproduktion af VEGF, som stimulerer til karnydannelse. Disse nye kar er små og skrøbelige, og brister nemt.
Der ses altså mikroaneurismer, præretinale karnydannelse. Cotton wool spots er resultatet af iskæmi og den deraffølgende overprofuktion af VEGF som tegn på små infarkter i retinae.
Atrofiske forandringer ses ved AMD. Spiculae har jeg endnu ikke hørt om.
Hvilke risikofaktorer disponerer for nethindeløsning?
- Presbyopi.
- Intraokulær kirurgi.
- Katarakt.
- Myopi.
- Våd AMD.
Svarmuligheder:
A. 1+2+5
B. 2+3
C. 1+3+5
D. 2+4
E. 3+5
D. 2+4
Note:
Risikofaktorer til amotio retinae:
- køn: det at være mand
- stigende alder
- øjenkirurgi
- øjentraume
- myopi
Du tilser en 83-årig kvinde på øjenafdelingen. Hun klager over tiltagende dårligt syn over det sidste år. Hun har især svært ved at læse avisen og bliver ofte blændet af modkørende bilister om aftenen. Desuden synes hun, at hun ser dårligere i mørke. Adspurgt har der ikke været smerter, rødmen i øjet eller metamorforpsier. Patienten bruger almindelige læsebriller, men ellers har synet altid været godt.
Visus o.dx.: 0,5 (6/12) med -0,50 sf.
Visus o.sin.: 0,33 (6/18) med -0,75 sf.
Spaltelampeundersøgelse og oftalmoskopi viser følgende:
(Foto)
Hvilken diagnose er mest sandsynlig?
A. Tør AMD
B. Våd AMD
C. Amotio retinae
D. Anterior uveit
E. Katarakt

E. Katarakt
Note:
Hun har svært ved at læse avisen (langsynet), bliver blændet af lys om aftenen, ser dårligt i mørke, ingen smerter, rødme eller metamorfsier.
A: Forkert - der er ingen lipidaflejringer (druser). Desuden er blæding om aftenen ikke et klassisk symptom.
B: Forkert - der er ingen lipidaflejringer + ingen metamorfopsier (linjer bliver bølgede), som ellers er et klassisk symptom.
C: Forkert - ved nethindeløsning For det første vil det højre billede ikke se sådan ud. Dernæst vil klassiske symptomer være synsfeltindskrækning med en skygge der bevæger sig langsomt.
D: Forkert - der vil være ciliær injektion.
E: Korrekt - meget klassisk med udviklet over en periode og helt karakteristisk med at det bliver svært at se i mærke og man bliver nemt blændet.
Hvilke to strukturer i øjet er overvejende ansvarlige for lysets brydning?
A. Corpus vitreum + retina.
B. Lens + corpus vitreum.
C. Cornea + iris.
D. Cornea + lens.
E. Iris + retina.
D. Cornea + lens.
+ kammervæsken
En 42-årig kvinde opdager pludseligt, at det hvide i hendes højre øje er kraftigt rødfarvet. Egen læge finder normalt visus, men udtalt forhøjelse af blodtrykket. Mest sandsynlig diagnose?
A. Hyphæma.
B. Akut glaukom.
C. Akut infektiøs konjunktivitis.
D. Subkonjunktival hæmoragi.
E. Akut iridocyklitis.
D. Subkonjunktival hæmoragi.
Note:
A: Hyphæma er en blødning i øjets forreste kammer - det er således ikke det “hvide” i øjnene.
B: Glaukom er degeneration af synsnerven med karakteristiske synsfelttab ofte associeret med forhøjet IOP. Der er således klassisk blødning i “det hvide” i øjnene.
C: Her vil der være tale om en form for konjunctival injektion - så rødme af øjet. Jeg synes, at “kraftig rødfarvet” tyder mere på en devideret blødning.
D: Stemmer overens med blødning samt forhøjet blodtryk som jo kan medføre at kar nemmere brister.
E: Her vil der være tale om ciliær injektion. Se svar C.
Hvad er førstevalgsbehandling af åbenvinklet glaukom?
A. Tryksænkende øjendråber.
B. Filtrerende kirurgi.
C. YAG-laser kapsulotomi.
D. Peroral tryksænkende behandling.
E. Brillekorrektion.
A. Tryksænkende øjendråber.
Note:
Glaukom er en degeneration af synsnerven med ledsagende karakteristisk synsfeltudtab. Ofte er tilstanden associeret med forhøjet intraokulært tryk. Lige netop åbenvinklet glaukom kan sagtens forekomme med normal IOP dog.
Behandlingen går ud på at sænke trykket. Det kan man gøre på forskellige måder:
Hæmme produktionen af kammervæske:
- betablokkere
- acetaxolamid
- alfa-adrenerge stoffer
- Diodelaser
Øge afløbet af kammervæske:
- PGE-analoger
- Cholinerge medikamenter
- laser
- trabekolektomi
SÅ! Valget står jo mellem A og D, men det er lokal behandling og ikke peroral.
Hvilket af følgende udsagn om tør AMD er ikke korrekt?
A. Der er evidens for, at vitamintilskud i rette mængder kan nedsætte risiko for sygdomsprogression.
B. Intravitreal angiostatisk terapi (anti-VEGF) virker hos 1/3 af patienterne.
C. Sygdommen kan være kendetegnet ved makulære druser og geografisk atrofi.
D. Sygdommen optræder sjældent hos personer under 50 år?
E. Patienterne kan være generet at tab af farvesyn og centrale skotomer.
B. Intravitreal angiostatisk terapi (anti-VEGF) virker hos 1/3 af patienterne.
Note: Det er våd AMD!!!
En 25-årig mand henvender sig i skadestuen med smerter og sløret syn svarende til højre øje. Hvilket spørgsmål til patienten vil have mindst relevans?
A. Har du slebet med vinkelsliber?
B. Har du bemærket sekret og klistrede øjenlåg?
C. Er der gigtsygdomme i familien?
D. Har du smerter i skulder-nakke åget?
E. Har du hamret på en mejsel?
D. Har du smerter i skulder-nakke åget?
Hvilken diagnostisk undersøgelse er mest relevant hos patienter med tæt corpushæmoragi?
A. Intraokulær trykmåling.
B. Motilitetsundersøgelse.
C. Ultralydsundersøgelse.
D. Spaltelampeundersøgelse.
E. Synsfelt for hånd.
C. Ultralydsundersøgelse.
1-1
Du er reservelæge i almen praksis. Ulla på 35 år henvender sig pga. sløret syn på højre øje gennem ca. en måned. Synet er kun lidt sløret, men det kan forværres, når hun er ude at løbe. Hun synes ikke øjet har været rødt, og det gør ikke decideret ondt – dog er det lidt ømt bag øjet, når hun bevæger det. Hun har ikke dobbeltsyn. Bruger ikke kontaktlinse. Har ikke tidligere fejlet noget med øjnene. Nogle gange kan det snurre i højre arm. Hun får ingen medicin, og er ellers rask.
Objektiv undersøgelse:
Visus o.dx.: 0,66 (6/9).
Visus o.sin: 1,00 (6/6).
Inspektion: Blegt øje.
Motilitet: Normal ved H-konfiguration, men ømhed i yderpositioner.
Stilling: Ingen skelen ved tildækningsprøven.
Pupiller: Normal lysrefleks, men højresidig relativ afferent pupildefekt (RAPD).
Hvad er din tentative diagnose?
A. Presbyopi.
B. Arteritis temporalis.
C. Myasthenia gravis.
D. Opticus neurit.
E. Anterior uveitis.

D. Opticus neurit.
Note:
Betændelse i synsnerven er karakteriseret ved smerter/ømhed ved bevægelse samt RAPD.
Tilstanden remitterer spontant, men steroid kan forkorte sygdomsforløbet.
1-2
Du henviser til øjenlæge på mistanke om højresidig opticus neurit.
Øjenlægen konstaterer let nedsat visus, påvirket farvesyn, ømhed ved motilitet og relativ afferent pupil defekt på højre øje. Ved oftalmoskopi af venstre øje ses normale forhold. Ved oftalmoskopi af højre øje ses følgende:
(Foto)
Hvad ser du?
A. Stort papilødem.
B. Normalt fundusfoto.
C. Bagre uveitis forenelig med toxoplasmose.
D. Arteritisk anterior iskæmisk opticusneuropati med blegt papilødem.
E. Retinitis pigmentosa.

B. Normalt fundusfoto.
Note:
Fundusfoto vil ofte være normalt ved opticusneurit, evt. papilødem - men det er der ikke på det pågældende billede.
1-3
Øjenlægen mistænker retrobulbær opticus neurit og henviser til neurologisk afdeling.
Kort tid efter besøget hos øjenlægen, udvikler hun horisontalt dobbeltsyn og har nu pludselig svært ved at adducere det højre øje.
Hvad er den mest sandsynlige forklaring herpå?
A. Internukleær oftalmoplegi.
B. Arteritisk anterior iskæmisk opticus neuropati.
C. Amblyopi som følge af opticus neuritis.
D. Horners syndrom.
E. Abducensparese.
A. Internukleær oftalmoplegi.
2-1
En 37-årig mand er på skovtur med familien og får ved et uheld en gren svirpet mod højre øje. Det bløder fra øjet, og synet er sløret. Han henvender sig i skadestuen.
Objektivt:
Visus o.dx: 0,6 (6/9).
Visus o.sin: 1,0 (6/6).
Eksterna: Se billede 1.
Inspektion: Farvning af cornea med fluorescein (billede 2), øjets forreste afsnit (billede 3)
(Fotos)
Hvilke skader er der på højre øje foruden læsion af øjenlågskanten?
A. Abrasio cornea og hypopion.
B. Hypopion og irisdialyse.
C. Abrasio cornea og hyphaema.
D. Tårevejslæsion og hyphaema.
E. Tårevejslæsion og irisdialyse.

C. Abrasio cornea og hyphaema.
Note:
Billede 2: Farven binder kun der hvor der er læsioner på cornea.
Billede 3: hyphæma - man kan se blod i forreste kammer.
2-2
En 37-årig mand får ved et uheld en gren svirpet mod højre øje og pådrager sig en øjenlågslæsion involverende øjenlågskanten, korneal abrasio og et lille hyphaema. Han bliver henvist til øjenafdelingen, hvor øjenlågslæsionen sutureres. Ved supplerende øjenundersøgelse findes:
Tension højre øje: 20 mmHg.
Tension venstre øje: 16 mmHg.
Oftalmoskopi: Normale nethindeforhold i begge øjne.
Patienten har meget ondt i højre øje.
Hvilke af nedenstående udsagn er korrekte?
- Der er indikation for lokalantibiotiske øjendråber.
- Der er indikation for operativ fjernelse af hyphaema.
- Der er øget risiko for trykstigning i øjet grundet hyphaema.
- Der er indikation for at udskrive oxybuprocain mod smerter.
- Der er indikation for mydriatikum for at hindre reblødning.
Svarmuligheder:
A. 1+2+5
B. 1+3+4
C. 1+3+5
D. 2+3+4
E. 2+3+4+5
C. 1+3+5
Note:
A: korrekt - pga. abrasio cornea. Det er for at indgå keratit.
B: forkert - det svinder af sig selv i løbet af 3-7 dage. Man skal blot holde sig i ro for at hindre reblødning.
C: korrekt - måske fordi traumet har risikeret at lukke kammervinklen?
D: forkert - det skal aldrig udskrives med hjem
E: korrekt - mydriatikum og man kan også give steroid.
2-3
En 37-årig mand får ved et uheld en gren svirpet mod højre øje og pådrager sig en øjenlågslæsion, der sutureres på øjenafdelingen. Grundet korneal abrasio opstartes behandling med lokalantibiotika. Der er risiko for trykstigning i øjet grundet hyphaema. Der er endvidere risiko for reblødning, hvorfor der udskrives recept på mydriatikum, og patienten får en opfølgende tid til kontrol i øjenambulatoriet 3 dage senere.
De følgende måneder oplever patienten flere episoder med smerter der starter om natten eller om morgenen, når han står op. Smerterne forsvinder i løbet af dagen.
Hvad er den mest sandsynlige årsag til smerterne?
A. Der er begyndende glaslegemesammenfald med træk på nethinden
B. Recidiverende abrasio
C. Traumatisk glaukom
D. Traumatisk anterior uveitis
E. Traumatisk udløste irisspasmer
B. Recidiverende abrasio
Note:
Recidivernde abrasio = grundet smerter om morgenen når han står op.
Tilstand med arvævsdannelse og ustabilt epithel grundet tidligere abrasio - øjenåbning (som når man vågner om morgenen) kan rive op i abrasionen igen og give anledning til symptomer.
2-4
Hvilken af nedenstående komplikationer ser man sjældent efter et stumpt traume?
A. Traumatisk nethindeløsning.
B. Traumatisk katarakt.
C. Blow-out fraktur.
D. Symblefaron.
E. Bulbusruptur.
D. Symblefaron.
Note:
Symblefaron er en sammenvoksning af økenlåg og øjenæblet (se vedhæftede billede). Det er svært at forestille sig dette på baggrund af et stump traume.

3-1
Du er KBU-læge i almen praksis og tilser en patient på 72 år, som har bestilt en akuttid på grund af akut opståede, kraftige ensidige øjensmerter. I begyndelsen var der regnbuesyn omkring lyskilder, men nu ser han kun håndbevægelser på det afficerede øje. Patienten klager ligeledes over ipsilateral hovedpine og kvalme. Han har aldrig prøvet noget lignede og er normalt sund og rask.
Hvad er din tentative diagnose?
A. Anterior uveit.
B. Retinal veneokklusion.
C. Vinkellukningsglaukom.
D. Keratitis.
E. Okulær migræne.
C. Vinkellukningsglaukom.
Note:
Akut opståede synspåvirkning ledsaget af smerter. Desuden regnbuesyn. Klassisk lukket-vinklet glaukom af akut type.
Hurtigt opståede synspåvirkning, smerter, ciliær injektion, regnbuesyn, lysstiv middeldilateret pupil, evt. kvalme/opkastninger.
3-2
Tidligere oplyst:
Du er KBU-læge i almen praksis og tilser en patient på 72 år, som har bestilt en akuttid på grund af akut opståede, kraftige ensidige øjensmerter. I begyndelsen var der regnbuesyn omkring lyskilder, men nu ser han kun håndbevægelser på det afficerede øje. Patienten klager ligeledes over ipsilateral hovedpine og kvalme. Han har aldrig prøvet noget lignede og er normalt sund og rask.
Du kommer i tanke om, at pupillerne også skal undersøges. Hvad forventer du at finde?
A. Runde, lige store pupiller, der er normalt reagerende for lys på begge øjne.
B. En middeldilateret, lysstiv pupil på det afficerede øje.
C. En lille, lysstiv pupil på det afficerede øje.
D. Fuldt dilaterede, lysstive pupiller på begge øjne.
E. Normale pupilforhold på det afficerede øje, men dilateret pupil på det symptomløse øje.
B. En middeldilateret, lysstiv pupil på det afficerede øje.
3-3
Patienten bliver set akut på øjenafdelingen, hvor den objektive undersøgelse er forenelig med vinkellukningsglaukom. Objektivt findes ciliær injektion og svært forhøjet øjentryk. På grund af kornealt ødem er det svært at visualisere forreste kammer, iris, linse og pupil. Det forhøjede øjentryk behandles medicinsk. Efter et par timer er øjentrykket normaliseret, og det korneale ødem er aftaget tilpas meget til, at iris, linse og pupil kan ses.
Hvad vil du nu gøre:
A. Sende patienten hjem med opfølgning ved egen øjenlæge.
B. Sende patienten hjem med tryknedsættende øjendråber med opfølgning ved egen øjenlæge.
C. Foretage YAG-laser iridotomi.
D. Patienten bookes akut til operation og får foretaget filtrerende glaukomoperation.
E. Foretage akut SLT (selektiv laser trabekuloplastik).
C. Foretage YAG-laser iridotomi.
Note:
Der laves et hul i regnbuehinden, hvilket åbner den snævre vinkel og fremover vil afløbet af kammervæske være bedre.
i og med at vinklen er lukket er man nødt til at finde en måde det kan passere på.
3-4
Hvilket udsagn om vinkellukningsglaukom er falsk:
- Langsynethed og stigende alder er en risikofaktor for akut vinkellukningsglaukom.
- Akut vinkellukningsglaukom forsøges initialt behandlet med bl.a. carbonanhydrasehæmmere, betablokkere og alfa-2-agonister.
- Det akut forhøjede øjentryk vil altid forårsage permanent skade på fotoreceptorer, således at visus permanent nedsættes.
- Man benytter gonioskopi til at vurdere, om kammervinklen er åben eller lukket.
- Cup-disk forholdet afhænger af papillens størrelse.
- Det akut forhøjede øjentryk vil altid forårsage permanent skade på fotoreceptorer, således at visus permanent nedsættes.
3-5
3 måneder efter ses patienten til kontrol efter synsfeltsundersøgelse (perimetri), som viser følgende (venstre øje: venstre tegning; højre øje: højre tegning):
Hvordan skal perimetrien tolkes?
A. Nedsat synsfelt i øvre kvadranter på det venstre øje.
B. Nedsat synsfelt i nedre kvadranter på det venstre øje.
C. Nedsat synsfelt i øvre kvadranter på det højre øje.
D. Nedsat synsfelt i nedre kvadranter på det højre øje
E. Normalt synsfelt på højre øje.

C. Nedsat synsfelt i øvre kvadranter på det højre øje.


